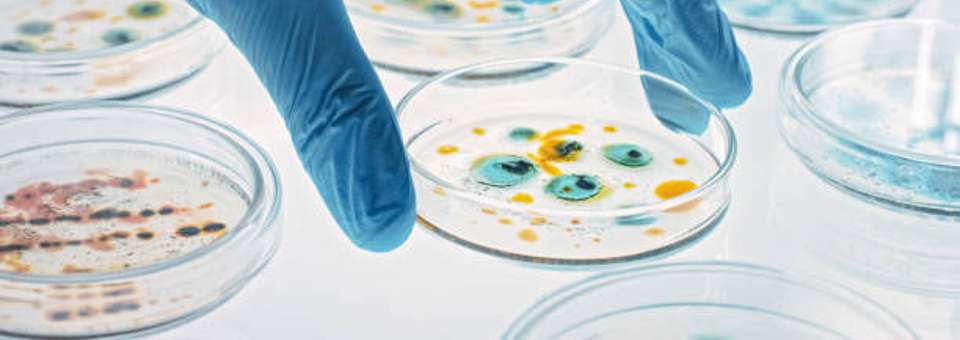

Dietary Supplement Testing
High-quality testing services tailored to the dietary supplement industry
ACCU Vita Labs is your trusted partner for high-quality testing services in the nutraceutical and supplement industry. We provide swift and accurate results through advanced facilities, using a comprehensive range of chemical, physical, and microbiological analyses. Rigorous laboratory testing must be done to confirm the absence of adulteration and contamination, including pathogens, residual solvents, and heavy metals.